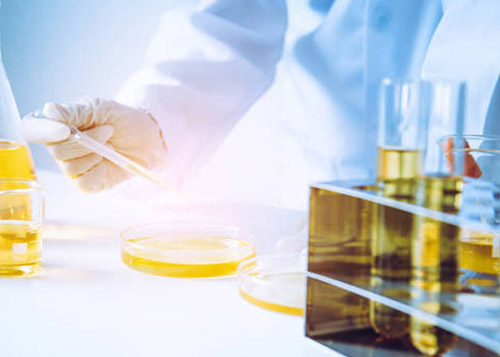

公司名稱(chēng):南京安美醫藥科技有限公司
公司地址:南京市玄武區玄武大道699-8號9幢
電話(huà):025-84767922
手機:18936879710
郵箱:sales@abydoscientific.com sales@abydospharma.com
QQ:1910587738
南京安美醫藥科技有限公司 版權所有(C)2022 網(wǎng)絡(luò )支持 中國化工網(wǎng) 全球化工網(wǎng) 生意寶 著(zhù)作權聲明 生意社 備案字號:蘇ICP備12000012號